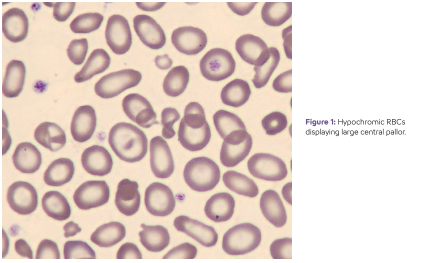
Hematology- Overview Anemia- Image #1

Hematology Overview - Anemia
Download PDF
Anemia is a global public health issue affecting an estimated one-third of the world’s population, with women and young children being predominantly concerned. According to the World Health Organization (WHO), anemia is a condition in which the number of red blood cells (RBC) or the RBC’s capability of carrying oxygen is reduced, resulting in an insufficient oxygen supply to meet the individuals’ physiological demand. To diagnose anemia, the hemoglobin (Hb) concentration is an effective screening tool. Appropriate Hb cutoffs were first published in 1968 by a WHO expert group and defined anemia as < 13 g/dL for healthy males, < 12 g/dL for healthy females, and < 11 g/dL for pregnant women and children under 5 years.1 Accordingly, fertile women are a vulnerable group for the potential development of anemia, along with children, elderly people and patients with chronic diseases.
Typical anemia symptoms include fatigue, shortness of breath, tachycardia and headache. These may be mild but can lead to a serious reduction in the individual’s quality of life. In the long term, permanently insufficient oxygen supply caused by untreated anemia may seriously impair organ function. Therefore, detecting pre-anemic conditions and diagnosing anemia in an early stage can facilitate a timely intervention to prevent irreversible damage. The most common type of anemia is iron deficiency anemia (IDA). Other anemia types result from vitamin deficiencies, blood loss events and infectious/chronic diseases. IDA can often be treated by nutritional iron supplementation, while patients with hemolytic, aplastic or myelodysplastic anemia subtypes or anemia of chronic disease (ACD) require precise differential diagnosis for adequate medical treatment to prevent the anemia from becoming more severe.
The value of indices
Differential diagnosis usually requires a morphological classification of RBCs. This can often be achieved through measurement of the RBC indices. Mean corpuscular volume (MCV), which reflects the average volume of red blood cells in a sample, helps to distinguish between microcytic, normocytic and macrocytic anemia. Normal MCV values range between approximately 80 and 100 fL. Impaired hemoglobin production, which is typical of IDA and β-thalassemia, results in microcytic RBCs with MCV values < 80 fL. In contrast, MCV values > 100 fL are mainly associated with abnormal erythropoiesis that may be seen in vitamin B12 and folate deficiencies or myelodysplasia. Normocytic anemia, on the other hand, is characterized by normal MCV values and a reduced number of RBCs due to acute bleeding, hemolysis and/or chronic diseases.
Another of the RBC indices, mean corpuscular hemoglobin concentration (MCHC), indicates the average amount of hemoglobin in each red blood cell relative to its volume. Normal MCHC values typically range from 32 to 36 g/dL. When the MCHC is < 32 g/dL, cells are usually considered hypochromic and may display a larger than normal central pallor when viewed on a stained peripheral blood smear (Figure 1, pdf)). Hypochromia is commonly associated with IDA, but may also be seen in thalassemia and/or anemia of chronic diseases. However, hyperchromia is uncommon and not generally associated with a specific anemia.
Advanced RBC parameters
Hemoglobin concentration and morphological RBC classification provide valuable clinical insights into anemia status, especially if iron or vitamin deficiencies are involved. Hence, efficient medical intervention depends on precise differential diagnosis. In addition to RBC indices, Sysmex’s XN-Series™ and select XN-L Series™ analyzers can provide advanced RBC parameters that can assist clinicians in assessing patients with anemia. A dedicated reticulocyte channel on these analyzers provides the additional Immature Reticulocyte Fraction (IRF) and Reticulocyte Hemoglobin Equivalent (RET-He) parameters that supply information about the rate of RBC production and hemoglobin content in the newly formed reticulocytes, respectively. This additional information may help physicians determine the cause of anemia and/or monitor treatment of their patients. Resources 1Guideline on haemoglobin cutoffs to define anaemia in individuals and populations. World Health Organization. August 2, 2024.https://www.who.int/publications/i/item/9789240088542
Sigue leyendo Download PDF